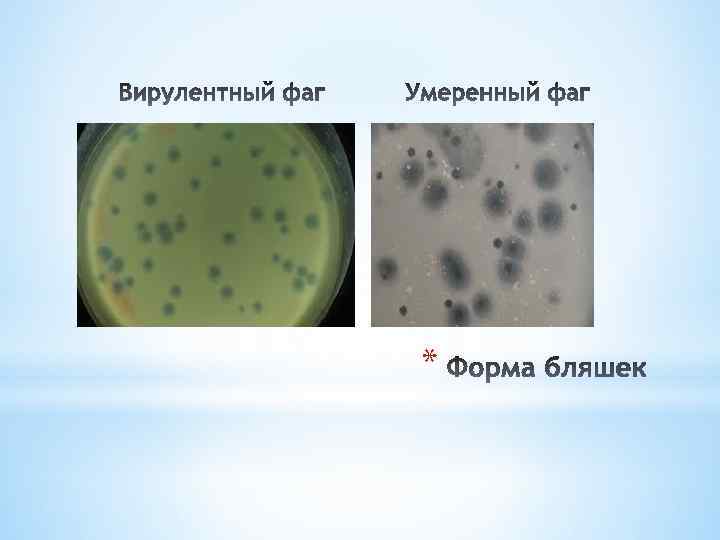
*

Вирусы в биотехнологии[1].pptx
- Количество слайдов: 58

* Лекция профессора Бойченко М. Н.

*Субвирусные инфекционные агенты: *1. вироиды *2. саттелиты *

*Вироиды – маленькие однонитевые кольцевые молекулы РНК, не кодирующие вирусные белки, лишенные белкового капсида * Термин предложен в 1971 г. Американским ученым Теодором Динером *

*Вироиды заражают высшие растения *Им не нужен вирус-помощник *Реплицируются в ядре или в хлоропластах с помощью клеточного фермента ДНКзависимой РНК-полимеразы *РНК вироидов обладает выраженной вторичной структурой, что обеспечивает высокую устойчивость к нуклеазам клетки и позволяет выживать без защитной белковой оболочки *

* Классификация основана а первичной нуклеотидной последовательности в РНК *В настоящее время определены 30 вироидов, которые объединены в 8 родов и 2 семейства: Pospiviroidae Avsunviroidae *Pospiviroidae ( potato spindle tuber viroid – вироид веретиновидности клубней картофеля) * Avsunviroidae ( avocado sunbloth viroid – вироид солнечной пятнистости авокадо) *

*Pospiviroidae реплицируются в ядре клетки, используя клеточные ДНК-зависимую РНК-полимеразу, а также эндонуклеазу и лигазу. Высоко структурированы *Avsunviroidae реплицируются в хлоропластах, используют только ДНК-зависимую РНК-полимеразу, так как РНК обладает рибозимной активностью и может катализировать процессы расщепления и лигирования молекул РНК. Менее структурированы *РНК вироидов не кодирует белки. В ее cоставе нет инициаторного кодона AUG *После репликации молекулы РНК мигрируют в цитоплазму и проникают в другие клетки. *От одного растения к другому вироиды распространяются при вегетативном размножении (Pospiviroidae) , а также с пыльцой и семенами (Avsunviroidae) *

*Патогенность вироидов связывают с влиянием вироидной РНК на синтез белка. *Вироиды, реплицирующиеся в ядре влияют на процессинг м-РНК, препятствуя выщеплению интронов. * Возможно, вироиды нарушают синтез рибосомной РНК, а также влияют на котрансляционый транспорт белков *

*Саттелиты –субвирусные агенты, неспособные заражать хозяйские клетки без вируса-помощника *Саттелиты реплицируются на матрице своей собственной нуклеиновой кислоты. Репликация саттелита происходит только в присутствии и полностью зависит от размножения вируса-помощника *Среди саттелитов различают: 1. саттелитные нуклеиновые кислоты( когда нуклеиновые кислота одевается в белокоболочки вируса-хозяина) *2. вирусы-саттелиты, у которых нуклеиновая кислота саттелита кодирует собственный белок оболочки и одевается в него с образование вирионов *

*Саттелиты встречаются у вирусов растений, грибов, бактерий, животных. Они обладают рядом общих свойств: *1. Генетичекий материал представлен нуклеиновой кислотой, размером от 200 до 2000 нуклеотидов *2. Н. к. не имеет гомологии с н. к. вируса-помощника *3. Саттелитные нуклеиновые кислоты обладает сложной вторичной структурой, которая защищает их от действия клеточных нуклеаз, что помогает им выжидать в ожидании вируса-помощника *Вирусы-саттелиты и саттелитные нуклеиновые кислоты не могут самостоятельно реплицироваться, поэтому они сами по себе неинфекционны *

*ВИРУСОИДЫ – имеют кольцевые молекулы РНК, размером 350 нуклеотидов, которые одеваются вместе с вирусной РНК вируса-помощника в вирусную оболочку. В одну оболочку может быть упаковано до 50 молекул вирусоидной кольцевой ss РНК * Молекула РНК вирусоидов имеет выраженную вторичную структуру и обладает рибозимной активностью. * Вирусоиды не способны в отличие от вироидов к самостоятельной репликации. *Репликация вирусоидной РНК поисходит в цитоплазме *

*Прионы – инфекционные агенты белковой природы( Prions – Proteinaceous Infection Particles) Pr. Pc. Pr. Psc вызывающие у животных и людей губчатые ( спогиоформные) энцефалопатии *

* 1732 в Англии была описана болезнь овец скрепи (scrape- скоблить, тереться), при которой овцы начинали неистово чесаться, соскребая всю шерсть, и вскоре погибали. * 1933 г. Ирландия закупила в Германии большую партию овец. Начало заболевания под названием * 1954 г. Sigurdsson B. Прочитал цикл лекций в Лондонском университете. Ввел термин «медленные инфекции * В 1956 Д. Гайдушек описал болезнь –куру, обнаруженной в племени форе в Папуа-Новой Гвинеи, которая характеризовалась нарушением координации движения, приступами смеха, летальным исходом *

*

* В 1982 году Стенли Прузинер выдвинул гипотезу, что причиной губкообразных трансмиссивных энцефалопатий является белок. Он его выделил в чистом виде, заражая скрепи серийских хомячков и ввел термин прион, который обозначил Pr. P. В 1985 году открыл ген ( PRNP) , в котором записана аминокислотная последовательность белка. Этот ген был обнаружен у всех млекопитающих, птиц, рыб, рептилий) * Pr. P является высококонсервативным белком, сотоящим из 254 аминокислотных. остатка. У разных видов млекопитающих аминокислотная последовательность идентична на 80% * Является сиалогликопротеином. * Локализован на поверхности клетки, заякорен в богатую холестеролом мембрану клетки через гликопротеин *

*Синтезируется главным образом в нейронах. *Обнаружен в селезенке, лимфатических узлах, коже, ЖКТ, фолликулярных дендритных клетках, роговице глаза, дрожжах. *Главной особенностью является ЧУВСТВИТЕЛЬНОСТЬ к ПРОТЕАЗЕ *

*Молекула нормального приона состоит из 4 альфа-спиральных доменов, стабилизированных междоменными электростатическими взаимодействиями и S-S 1 – связью *В модифицированной изоформе приона Pr. Psc ( scrapie prion protein) в отличии от нормального прионного белка Pr. Pc первоначальную спиралевидную форму сохраняют только 2 домена: Н 3 и. Н 4. Остальные 2 домена: Н 1 и Н 2 превращаются в бета-тяжи, связанные друг с другом и доменам Н 3 и Н 4 * Именно С-терминальный участок конформационно измененной формы, Pr. Psc , становится резистентным к протеазе *

*Накопление конформационно измененного белка сопровождается: * его агрегацией, *образованием высоко упорядочных фибрилл (амелоидов), *приводит к гибели клетки *

*

*Именно С-терминальный участок конформационно измененной формы, Pr. Psc , становится резистентным к протеазе *Превращение нормального белка в патогенный Pr. Psc происходит или в результате генетических мутаций или в результате белок-белковых взаимодействий *Процесс усиливается при возрастании количества патологического приона, который образует агрегаты с собой и с Pr. Pc на поверхности клетки *В результате Pr. Pc превращается в прион Pr. Psc и далее цикл продолжается *

*

*Измененные прионы устойчивы : *1. к протеолизу * 2. к излучениям *3. к высокой температуре *4. к формальдегиду *5. к глютаральальдегиду *6. к бета-пропиолдактону * *


* Наличие прионов в дрожжах было установлено в 80 х годах * Представляют конформационные варианты обычных клеточных белков * В результате конформационной перестройки приобретают новые свойства: * способность к аггрегации за счет взаимодействия бетта-слоев и образованию амилоидов с переходом в нерастворимую форму * Устойчивость к протеазе * Теряют функциональную активность исходных белков. Клетка становится дефектной по функции белка предшественника приона *

*Дрожжевой транскрипционный ко-репрессор Ure-2 p может существовать в 2 стабильных конформационных формах: *1. активной как ко-репрессор (связывает и удаляет 2 транскрипционных активатора) *2. нерастворимой неактивной конформационной форме *3. Неактивная конформация обладает способностью быть матрицей для превращения протеина того же типа, с той же аминокислотной последовательностью в его собственную прионоподобную конформацию * *

*Бактерии рода Bartonella имеют геминсвязывающий белок (Hbp), входящий в мембрану клетки. *Является порин-подобным белком, обладающим спосоюностью связыватьгемин, делая бактерии геминзависимыми

*Прионы дрожжей не приводят к гибели клеток. *Они повышают выживаемость в неблагоприятных условиях *( Белок Sup 35, который является фактором терминации трансляции у Saccharomyces cerevisiae, прионизации перестает терминировать трансляцию, в результате образуется длинный полипептид, который позволяет дрожжам расти без аденина, таким образом изменяя метаболизм азота) *

*


*

* Продукт гена С I является репрессором, подавляющим работу промотеров PI и Prm. Он также создает иммунитет к фаговой суперинфекции Продукт гена cro обеспечивает синтез ферментов литического цикла Продукт гена CII вызывает интенсивный синтез СI. Ген CII находится под контролем ц-АМФ Ген xis обеспечивает исключение профаговой ДНК из ДНК бактерии Ген int обеспечивает включение фаговой ДНК в геном бактерии (переход в состояние профага)

*Продукт гена С I является репрессором, подавляющим работу промотеров PI и Prm. Он также создает иммунитет к фаговой суперинфекции *Продукт гена cro обеспечивает синтез ферментов литического цикла *Продукт гена CII вызывает интенсивный синтез С I. Ген CII находится под контролем ц-АМФ *Ген xis обеспечивает исключение профаговой ДНК из ДНК бактерии *Ген int обеспечивает включение фаговой ДНК в геном бактерии (переход в состояние профага) *

*

*В лизогенной бактериальной клетке на низком уровне происходит синтез репрессора СI *Если под действием УФ происходит удаление СI, начинается транскрипция с правого промотора Prm и левого промотора PI *Начинается синтез ранних белков Cro и N, которые индуцируют по ходу и транскрипцию генов xis и Q *Происходит исключение ДНК профага и синтез поздних белков , сборка фага и лизис клетки *

*В «голодной» бактериальной клетке находится высокий уровень ц-АМФ, который активирует ген СII , продукт которого стимулирует интенсивный синтез СI, в результате происходит интеграция фаговой ДНК в геном бактерии *Накопившейся белок СI подавляет синтез белка СII и уровень СI находится на уровне поддержания лизогении *При уменьшении концентрации ц-АМФ, синтез белка СII падает. Начинает доминировать синтез белка Cro, а не СI. *Развитие фага идет по литическому пути *
*

*

*Фаговая конверсия имеет значение в медицине: лизогенными бактериями вырабатываются эритрогенный токсин возбудителя скарлатины; дифтерийный токсин, ботулинический токсин. *У полилизогенной культуры стрептомицетов - продуцентов антибиотиков, содержащей 4 профага, один кодировал синтез антибиотика. * * Лизогенная (фаговая) конверсия

*Благодаря концентрации больших количеств микробных клеток обеспечение стабильности биотехнологических производств зависит от исключения проявления процессов фаголизиса. *Фаголизис могут вызвать как вирулентные фаги, так и умеренные фаги, как при спонтанной индукции профага у лизогенных бактерий, так и при мутациях к вирулентности умеренных фагов. * При использовании для культивирования биообъекта периодического или непрерывного способа культивирования в защищенных (стерильных) условиях решение проблемы фаголизиса заключается в выборе нелизогенного штамма-продуцента. *

*При использовании нового штамма-продуцента предварительно необходимо проводить его тестирование на лизогенность *Для этого используемый штамм подвергается воздействию возможных индуцирующих факторов: УФ, гаммаизлучения, химических мутагенов, а также различных концентраций питательных элементов среды культивирования * Если производственно ценные признаки лизогенного штамма превосходят таковые нелизогенного, и его следует использовать в производствае, то для обеспечения стабильности производства необходимо точное соблюдение правил культивирования для исключения спонтанной индукции профага. *

*Для производства важно определение характера бактеритофагов, лизирующих производственную культуру, а также источник инфицирования фагами. *Основным источником поступления фагов являются: * поступающие большие объемы воды, при высоком коэффициенте разбавления среды в ферментере * воздух при аэробных условиях культивирования * сырье, используемое при культивировании * *

*Источником инфицирования производства бактериофагами может быть и сырье, например- молоко при получении молочнокислых продуктов. Поэтому при производстве молочнокислых продуктов, в качестве путей предупреждения развития фага применяют: *Чередование в заквасках штаммов молочнокислых бактерий, нечувствительных к большому количеству типов бактериофагов, обнаруживаемых в биопроизводстве *Исключение из заквасок лизогенных штаммов *Добавление к молоку, используемому в производстве, «иммунного молока» , полученного от коров, иммунизированных бактериофагами и содержащего антитела к фагам *Тщательная мойка и дезинфекция оборудования, стен помещений. *

*Бактериофаги могут быть использованы для диагностики, идентификации выделенных бактерий *На чашку со средой, засеянной чистой культурой возбудителя, наносят различные диагностические бактериофаги. Если бактерия чувствительна к фагу, то образуется зона просветления. *Возбудитель может быть чувствителен к одному или нескольким фагам. *Спектр чувствительности возбудителя к фагом называют фаготипом, а метод диагностики –фаготипированием *

*

*Наличие фагов кишечной палочки и возбудителей кишечных инфекций в водоисточниках является показателем их антисанитарного состояния и бактериального загрязнения. *Фаготерапия *Препараты бактериофагов точечным ударом справляются с болезнетворными микробами, а уничтожив бактерии, самостоятельно выводятся из организма. Не нарушая работу органов не вызывая побочных эффектов. Для проведения фаготерапии готовят препараты лечебно-профилактических бактериофагов *

*Лечебно-профилактические бактериофаги – антимикробные препараты, которые содержат высоковирулентные бактериальные фаги и обладают селективным антибактериальным действием *Преимущества: *1. обладают строгой специфичностью по отношению к чувствительным бактериям. *2. быстродействие. (Через 1 час бактериофаги после перорального введения обнаруживаются в крови, через 2 часа – в моче) *Самовоспроизведение. Пораженная клетка продуцирует сотни бактериофагов и лизируется *Полностью удаляются из организма в отсутствии бактерий, чувствительных к фагу. *

Лечебно-профилактические бактериофаги – антимикробные препараты, которые содержат высоковирулентные бактериальные фаги и обладают селективным антибактериальным действием Преимущества: 1. обладают строгой специфичностью по отношению к чувствительным бактериям. 2. быстродействие. (Через 1 час бактериофаги после перорального введения обнаруживаются в крови, через 2 часа – в моче) Самовоспроизведение. Пораженная клетка продуцирует сотни бактериофагов и лизируется Полностью удаляются из организма в отсутствии бактерий, чувствительных к фагу.

*1. Подбор активных природных фаговых клонов, не способных лизогенировать бактерию и обладающих более широким спектром литической активности в отношении штаммов данного вида бактерий *Накопление фагов путем заражения чувствительных бактерий, их последующего лизиса и выхода нового поколения фагов. *Очистка препарата от бактериального загрязнения *Используемые бактериофаги должны быть вирулентными и не вызывать фаговой конверсии *Перспективы – использование литических ферментов, кодируемых геномом фага, способных лизировать клетки патогенных бактерий *

*cosmid vector - космида. Векторная плазмида <plasmid>, содержащая cosучасток <cos-sites> ДНК фага лямбда, который является местом замыкания его линейной ДНК в кольцо, благодаря наличию соs-участка космидная (векторная) ДНК, включившая чужеродные гены, может быть упакована в головку бактериофага; метод клонирования ДНК с использованием К. разработан Дж. Коллинзом и Б. Хольмом в 1977. * *




*

*РГА позволяет обнаружить (провести индикацию )вирус: * в зараженном курином эмбрионе * культуральной жидкости зараженной вирусом культуре клеток *


*

*Вирионы могут быть реконструированы в пробирке из белка оболочки и нуклеиновой кислоты. Получают структуры, обладающие биологической активностью исходных вирусных частиц, способных к самосборке Реконструированные белки оболочки могут применяться в качестве строительных блоков для создания нанотрубок, наноконтейнеров *

* Белок оболочки бактериофага М 13 связали с аморфным фосфатом железа, способным обратимо присоединять и отдавать ионы лития. Такой бактериофаг селективно присоединяется к углеродным нанотрубкам, обладающим высокой электропроводностью. Получился аккумулятор, собранный на основе «вирусных» электродов. Благодаря процессу самосборки, электродам можно придать разную форму, встраивая в различные портативные устройства *

*На основе ВТМ было создано цифровое запоминающее устройство. К капсидным белкам вируса присоединили положительно заряженные наночастицы платины, которые были связаны с определенными карбоксильными и гидроксильными группами белков. При приложении электрического поля заряды перемещаются от оболочки к РНК или наоборот, но находятся все время в вирусной частице. *Вирус стал элементом энергонезависимой цифровой памяти *
Вирусы в биотехнологии[1].pptx